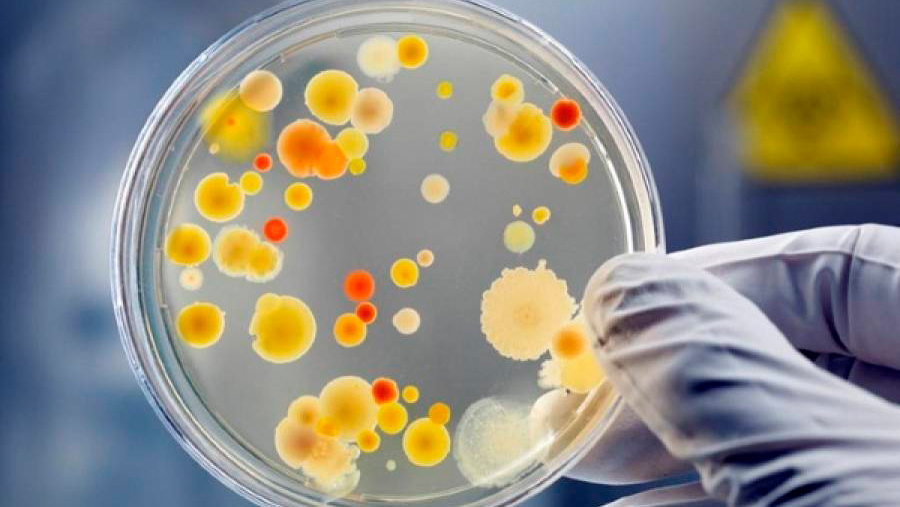
Інформує Лубенський підрозділ ДУ "«Полтавський обласний центр контролю та профілактики хвороб"

Слава Україні! Розпочалася 1182-га доба широкомасштабної збройної агресії російської федерації проти України.
Загалом, протягом минулої доби зафіксовано 177 бойових зіткнень. За уточненою інформацією, вчора противник завдав по позиціях українських підрозділів та населених пунктах 59 авіаційних ударів, скинув 117 керованих авіаційних бомб, залучив 2882 дрони-камікадзе. Також ворог здійснив 5366 артилерійських обстрілів, зокрема 157 – із реактивних систем залпового вогню.
Станом на ранок 20 травня 2025 року ситуація на території Лубенської громади стабільна та контрольована.